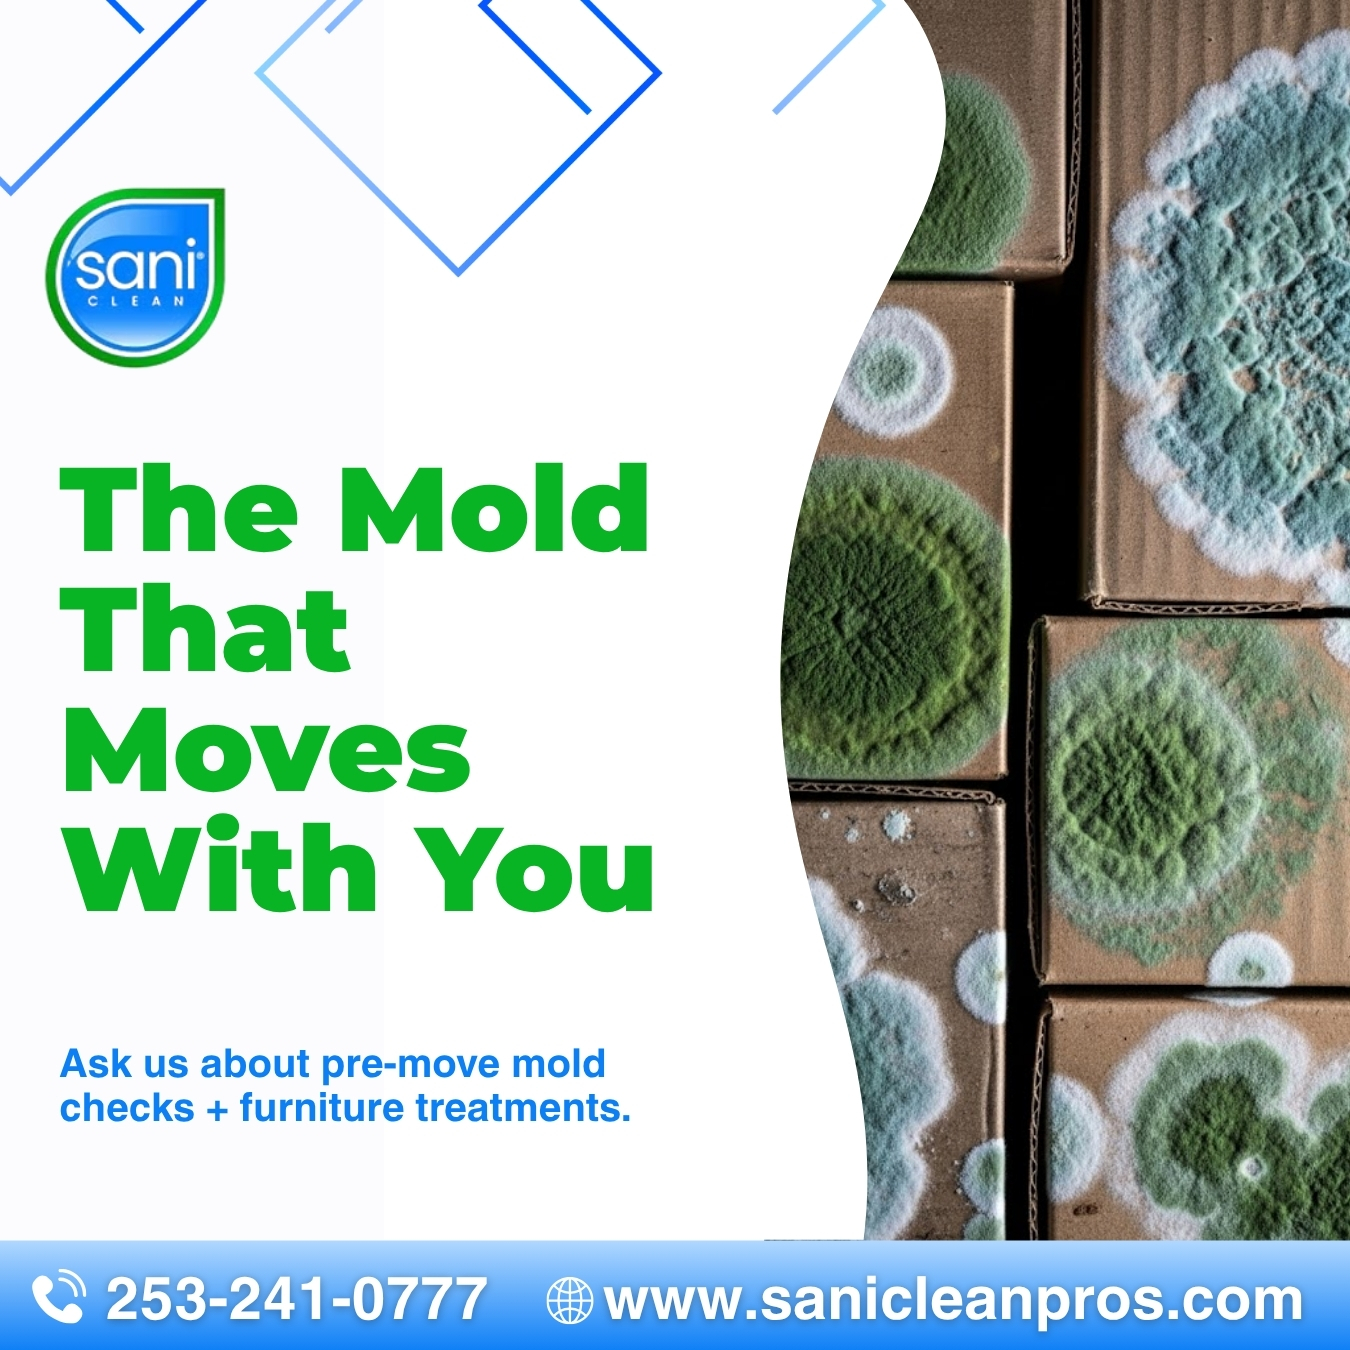

uberall
SaniClean Pros
9017 South J Street Tacoma, Washington, 98444
Last time updated: 10/12/25, 10:42 AM
About
SaniClean Pros is your trusted partner for swift and eco-conscious mold remediation and water damage restoration. We revitalize homes and businesses, creating safer, healthier environments with minimal disruption. By employing advanced, non-invasive technology, we address problems at the source, restoring your property and your peace of mind. Experience the SaniClean Pros difference, where expertise meets environmental responsibility.
Images

Frequently Asked Questions
Which days is SaniClean Pros open?
Open on Monday, Tuesday, Wednesday, Thursday, Friday, Saturday, Sunday.
Attention business owner!
Register your business now and enhance your global reach with iGlobal.
Copied to clipboard!